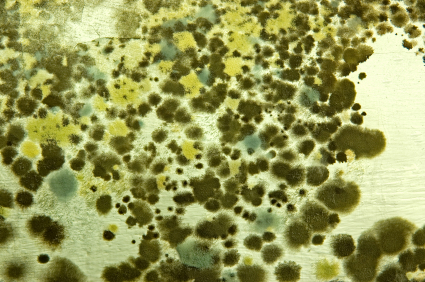

Dangers of House Mold
So what is mold exactly? Mold is a type of fungus that is essentially everywhere–in our homes, offices, outside, etc. Mold spores, which are tiny microscopic ‘seeds’, are everywhere, too–especially in damp areas of our homes, and even mixed in with dust. These mold spores can grow on just about anything if conditions are correct–i.e. some type of organic matter and water. Usually, if you see mold–it means there is a moisture problem somewhere close by.
The more alarming issue is having these mold spores floating around in our indoor air–which is something that should not be tolerated as mold spores can cause a whole range of allergic reactions, and some generalized, hard-to-identify illnesses. Over time, mold can even to asthma-like conditions in adults and children, with wheezing, coughing, and shortness of breath. Not to say that mold causes asthma, but it's spores and mycotoxins can irritate the bronchial tissues and other areas in the airway and create a similar reaction.
Symptoms of mold, other than a musty, mildew smell, may include coughing, wheezing, nasal and throat conditions, difficulty breathing, eye irritation, unexplained headaches, and more. People with asthma or allergies who are sensitive to mold spores may find that their symptoms are more severe. Even serious fungal respiratory infections can occur in those with weakened immune systems. Black mold, which produces mycotoxins, can even lead to nerve and brain disorders, and other very serious health conditions.
So if you see it, or even think you may have mold, test it to make sure of what is there, what type, and then take steps to remove it–and consult with a professional if you are not sure how to identify it or get rid of it.
Another great step to take is to add a professional-grade HEPA air purification system to your home, office, or wherever the mold is an issue. This kind of air purifier will remove 99.97 % of particles (including mold spores) down to a size of 0.3 microns, some down to 0.1 micron. For reference, mold spores typically range from 3-100 microns in size, some even as small as 1 micron. So you can see, a HEPA filter that removes particles down to 0.3 microns is more than enough in most cases. And don't forget to consider a dehumidifier. The humidity must be kept low enough to prevent growth / re-growth of mold.
Here are some ton-notch air purifiers and dehumidifiers that we sell and recommend (we do recommend that you select the UV option wherever possible as this provides extra protection from mold spores):